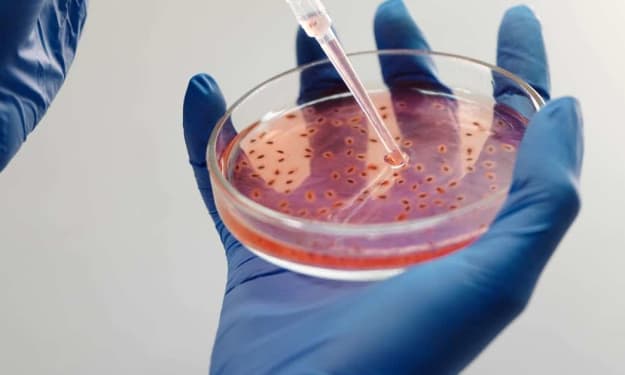

Biodefense Role in Homeland Security
Biological threats have the potential to endanger large populations and cause widespread panic. From anthrax to smallpox, pathogenic microorganisms deliberately used to harm humanity pose grave dangers.

Modern Biodefense Strategies
With advances in biotechnology, the potential for biological threats has increased. In response, governments and organizations have developed modern strategies for biodefense. These strategies aim to minimize biological risks and enhance preparedness through surveillance, prevention, and response capabilities.
Surveillance and Detection
A key element of Biodefense is effective disease surveillance. Only by closely monitoring potential outbreaks can authorities hope to detect biological incidents in their early stages. The U.S. employs a tiered system of global, national, state, and local surveillance networks. At the global level, the World Health Organization coordinates monitoring of emerging infectious diseases worldwide. Nationally, U.S. agencies like the CDC gather disease data and look for anomalies that could signal intentional release. State and local health departments also maintain surveillance programs tailored to their jurisdictions.
Advanced methods aid surveillance efforts. For example, genetic sequencing allows rapid identification of disease-causing agents. Syndromic surveillance uses non-specific indicators like emergency room visits to spot outbreaks sooner. Smartphone apps even enable crowdsourced reporting of potential symptoms. Collectively, these tools expand surveillance coverage and shrink detection timelines. Early identification is critical, as the impacts of biological events grow over time.
Countermeasures and Mitigation
Once a biological threat is confirmed, containment and mitigation strategies are activated. Stockpiles of vaccines, antiviral drugs, and therapeutic antibodies aim to counter common pathogens’ effects. The Strategic National Stockpile maintains these critical medical resources for rapid deployment anywhere in the U.S. Mobile containment equipment like quarantine tents and decontamination showers also stand ready to limit spread.
Non-pharmaceutical responses supplement medicine. Communication strategies coordinate public information sharing and issue guidance. Social distancing and isolation policies may slow an outbreak when advised. Decontamination of infected environments and disposal of exposed materials eliminate lingering risks. Military and civil support assets activate to assist hard-hit communities. Local emergency plans incorporate these varied tools for proportional and coordinated response.
Restricting Access
To curb biological risks at their source, access to pathogens must be restricted. The U.S. regulates research on select agents that pose severe threats. Labs manipulating such organisms face safety and security standards under the purview of the CDC and USDA. Unauthorized possession or transfer of regulated pathogens entails serious legal penalties. Export controls also apply to shipment of dangerous microbes overseas.
Beyond regulation, outreach programs aim to change attitudes enabling biological risks. They promote education on dual-use dilemmas and foster a culture prizing responsible life science work. International collaboration further constrains access worldwide, denying would-be actors materials and expertise. Although complete control remains impossible, prudent restrictions and norms comprise an essential part of modern biodefense. They balance research needs against containing biological hazards.
Future Challenges and Advances
While current practices have strengthened biodefense capabilities, future threats could evolve rapidly. Synthetic biology may enable entirely new pathogens to be engineered from publically available genetic sequences and reagents. Antibiotic resistance poses growing risks as more bacteria circumvent existing drugs. Furthermore, climate change could expand the ranges of disease-carrying insects and alter outbreak patterns.
Looking ahead, biodefense strategies will require constant adaptation. Promising areas for future improvement include enhanced global health security cooperation, next-generation vaccinations, rapid 3D printing of medical supplies, and advanced bioforensic techniques for identifying attackers. Continued surveillance innovation and faster diagnostics also feature among priorities. Most importantly, maintaining vigilance and a multidisciplinary biodefense mindset can help humanity stay steps ahead of evolving biological risks through cooperative international action.
Get More Insights on Biodefense- Biotechnology's Role in Homeland Security
For more understanding, choose your preferred language-
• French
• German
• Italian
• Russian
• Japanese
• Chinese
• Korean
• Portuguese
About Author-
Money Singh is a seasoned content writer with over four years of experience in the market research sector. Known for her strong SEO background, she skillfully blends SEO strategies with insightful content. Her expertise spans various industries, including food and beverages, biotechnology, chemical and materials, defense and aerospace, consumer goods, etc. (https://www.linkedin.com/in/money-singh-590844163)

Comments
There are no comments for this story
Be the first to respond and start the conversation.